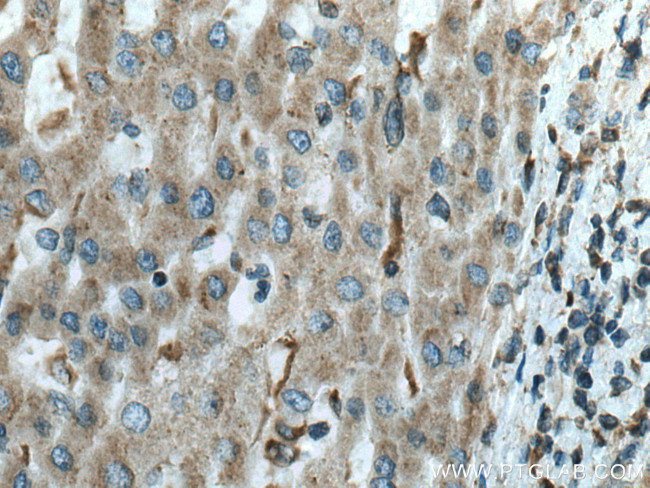
FUCA1 Antibody in Immunohistochemistry (Paraffin) (IHC (P))

Search
Proteintech
FUCA1 Monoclonal Antibody (1G5C5)
{{$productOrderCtrl.translations['antibody.pdp.commerceCard.promotion.promotions']}}
{{$productOrderCtrl.translations['antibody.pdp.commerceCard.promotion.viewpromo']}}
{{$productOrderCtrl.translations['antibody.pdp.commerceCard.promotion.promocode']}}: {{promo.promoCode}} {{promo.promoTitle}} {{promo.promoDescription}}. {{$productOrderCtrl.translations['antibody.pdp.commerceCard.promotion.learnmore']}}
产品信息
67251-1-IG
种属反应
宿主/亚型
分类
类型
克隆号
抗原
偶联物
形式
浓度
规格
纯化类型
保存液
内含物
保存条件
运输条件
产品详细信息
Aliquoting is unnecessary for -20°C storage.
靶标信息
Alpha-L-fucosidase (EC 3.2.1.51) is a lysosomal enzyme involved in the degradation of fucose-containing glycoproteins and glycolipids (Occhiodoro et al., 1989 [PubMed 2803312]). At least 2 separate polymorphic alpha-L-fucosidases are recognized in man: that in tissues, FUCA1, which is deficient in fucosidosis (MIM 230000), and that in plasma, FUCA2 (MIM 136820).[supplied by OMIM].
仅用于科研。不用于诊断过程。未经明确授权不得转售。
篇参考文献 (0)
生物信息学
蛋白别名: A L fucosidase I; A L fucoside fucohydrolase 1; a-L-fucosidase 1; alpha-L fucosidase; Alpha-L-fucosidase 1; Alpha-L-fucosidase I; alpha-L-fucosidase precursor (EC 3.2.1.5); Alpha-L-fucoside fucohydrolase 1; EC 3.2.1; EC 3.2.1.51; fucosidase, alpha-L- 1, tissue; fucosidase, alpha-L-1, tissue; I+/--L-fucosidase 1; Tissue alpha-L-fucosidase; tissue fucosidase; Tissue α L fucosidase; unnamed protein product; α L fucosidase 1; α L fucosidase I; α L fucoside fucohydrolase 1
基因别名: 0610006A03Rik; 9530055J05Rik; Afuc; FUCA; FUCA1; Nbla10230
UniProt ID: (Human) P04066, (Mouse) Q99LJ1
Entrez Gene ID: (Human) 2517, (Mouse) 71665